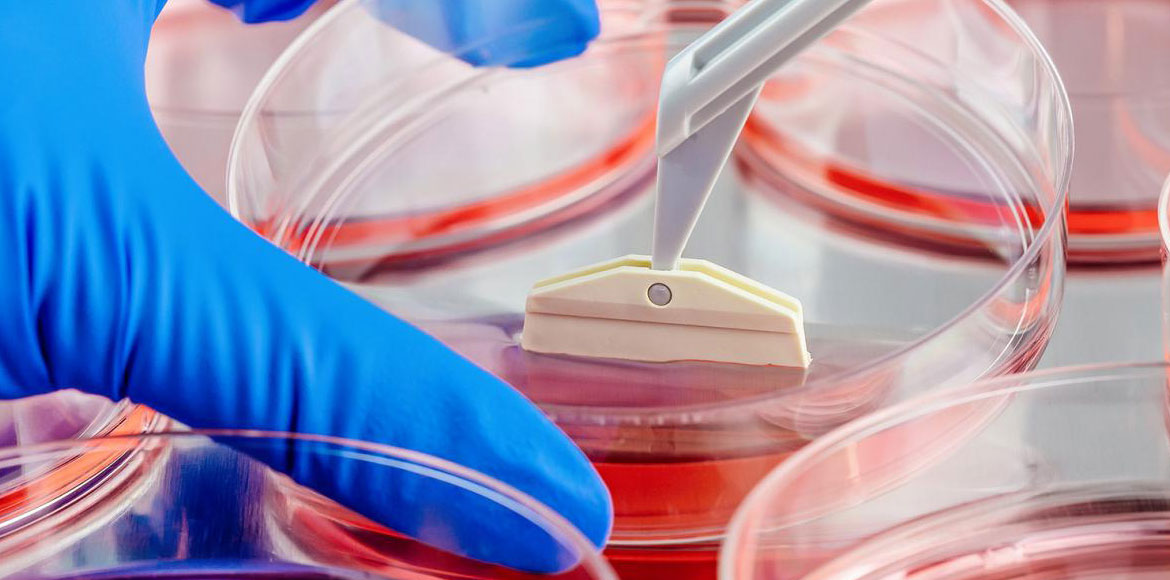
Cell Line Studies

Cell Line Studies
Animal Studies
Chromatographic Techniques
| S.No. | BASIC | ADVANCED |
|---|---|---|
| 1. | Adsorption chromatography | Affinity chromatography |
| 2. | Thin layer chromatography | Hydrophobic interactions |
| 3. | Ion exchange chromatography | High performance liquid chromatography (analytical and preparative) |
| 4. | Gel filtration chromatography | Ultra performance liquid chromatography |
| 5. | - | Gas chromatography mass spectrometry |
| 6. | - | Liquid chromatography mass spectrometry |
BIOCHEMICAL TESTS
| S.No. | CONTENT |
|---|---|
| 1. | Phytochemical screening |
| 2. | Amino acid screening |
| 3. | Estimation of Carbohydrate |
| 4. | Estimation of Lipid |
| 5. | Estimation of Vitamins |
| 6. | Ammonia |
| 7. | Calcium |
| 8. | Magnesium |
| 9. | Nitrate |
| 10. | Nitrite |
| 11. | Chloride |
| 12. | Phosphate |
| 13. | Sulphate |
| 14. | Methylene Blue Reductase Test |
| 15. | Catalase And Coagulase Test |
| 16. | Estimation Of Soil Mineral Content |
| 17. | Lecithinase Test |
| 18. | Carbohydrate Fermentation Test |
| 19. | Triple Sugar Iron Agar |
| 20. | Urease Test |
| 21. | Voges-Proskauer Test |
| 22. | Litmus Milk Test |
| 23. | DPPH - Antioxidant test |
BIOCHEMISTRY
| S.No. | CONTENT |
|---|---|
| 1. | Construction of Maltose Standard Curve by DNS Method |
| 2. | Construction of Protein Standard Curve using Folin’s Lowry Method |
| 3. | Effect of substrate concentration on enzyme kinetics |
| 4. | Effect of temperature on enzyme kinetics |
| 5. | Estimation of blood glucose by Glucose oxidase method |
| 6. | Estimation of saponification value of fats/ oils |
| 7. | Isoelectric precipitation of proteins: Casein from milk |
| 8. | Qualitative Analysis of Amino Acid |
| 9. | Qualitative analysis of carbohydrates |
| 10. | Quantitative Estimation of Amino Acids by Ninhydrin |
| 11. | Separation of Amino Acids by Thin Layer Chromatography |
| 12. | Titration Curves of Amino acids |
| 13. | Estimation of Blood Urea by Enzymatic Berthelot method |
ENVIRONMENTAL MICROBIOLOGY
| S.No. | CONTENT |
|---|---|
| 1. | Microbial degradation of cellulose |
| 2. | Isolation of coilforms from sewage |
| 3. | Analysis of TDS of effluent |
| 4. | Effect of high salt concentration on microbial growth |
FOOD ANALYSIS
| S.No. | CONTENT |
|---|---|
| 1. | Moisture |
| 2. | Fat |
| 3. | Oil |
| 4. | Food |
| 5. | Water |
| 6. | Fiber |
| 7. | Ash |
| 8. | Carbohydrate |
| 9. | Energy |
| 10. | Minerals(Na,K,Mg,Ca,Fe,Mn,Zn,Se,Cu,S,Mo,P) |
| 11. | Heavy metals analysis (Hg, Pb,As, and Cd) |
MICROBIOLOGY
| S.No. | CONTENT |
|---|---|
| 1. | Preparation of culture media |
| 2. | Sterilization |
| 3. | Cleaning and sterilization of glass wars |
| 4. | Aseptic technique and culture inoculation |
| 5. | Serial dilution technique |
| Pure Culture Techniques | |
| 6. | Pour plate method |
| 7. | Spread plate technique |
| 8. | Streak plate |
| 9. | Cultural variation of bacteria |
| 10. | Morphological variation of bacteria |
| Staining Techniques | |
| 11. | Smear preparation and fixation |
| 12. | Simple Staining |
| 13. | Staining |
| 14. | Gram staining |
| 15. | Negative Staining |
| 16. | Spore Staining |
| 17. | Acid fast Staining |
| 18. | Silver Staining |
| 19. | Motility test |
| 20. | Cultivation of anaerobes’ |
| 21. | Preservation microorganism |
IMMUNO TECHNIQUES
| S.No. | CONTENT |
|---|---|
| 1. | Antibody generation, |
| 2. | Detection of molecules using ELISA, |
| 3. | RIA |
| 4. | Western blot |
| 5. | Immunoprecipitation, |
| 6. | Luocytometry |
| 7. | Immunofluorescence microscopy, |
| 8. | FISH |
| 9. | GISH |
| 10. | Widal Test |
MICROBIAL PHYSIOLOGY
| S.No. | CONTENT |
|---|---|
| 1. | Measurement of growth and growth curve |
| 2. | Effect of growth |
| 3. | Effect of Temperature on growth |
| 4. | Effect of salinity on growth |
| 5. | Effect of sunlight radian on growth |
| 6. | Effect of Disinfectant (phenol test) |
MICROBIAL BIOTECHNOLOGY
| S.No. | CONTENT |
|---|---|
| 1. | Isolation of bacteria from soil |
| 2. | Isolation of fungi from soil |
| 3. | Isolation of actinomyceles from soil |
MICROSCOPIC TECHNIQUES
| S.No. | CONTENT |
|---|---|
| 1. | Visualization of cells and sub cellular components by light microscopy |
| 2. | Scanning electron microscopy |
| 3. | Transmission electron microscopy |
| 4. | Atomic force microscopy |
| 5. | Inverted microscopy |
| 6. | Florescence microscopy |
MOLECULAR BIOLOGY
| S.No. | CONTENT |
|---|---|
| 1. | Assessment of Dented Proteins by SDS PAGE Electrophoresis |
| 2. | Assessment of DNA by Agarose Gel Electrophoresis |
| 3. | Extraction of Bacteriophage DNA from Large Scale Cultures Using Proteinase K and SDS |
| 4. | Extraction of DNA from Agarose gel |
| 5. | Extraction of DNA from Fish Fins |
| 6. | Hot Shot Method of DNA Extraction |
| 7. | Isolation of RNA |
| 8. | Ligation ( Using T4 DNA Ligase) |
| 9. | Plasmid Curing |
| 10. | Plasmid Isolation (Mini prep) phage, cosmid, BAC and YAC vectors. |
| 11. | Polymerase Chain Reaction (PCR). |
| 12. | Preparation of Buffer stocks (TBE, TE and TAE) |
| 13. | Preparation of Competent Cell (Calcium Chloride Treatment) |
| 14. | Restriction Digestion |
| 15. | Transformation of the Host Cells |
| 16. | RFLP, RAPD and AFLP techniques |
PHARMACEUTICAL ANALYSIS
| S.No. | CONTENT |
|---|---|
| 1. | Preformulation Studies For Active Pharmaceutical Ingredient (Api) And Granules |
| 2. | Determination Of Particle Size Distribution Of Granules By Sieve Analysis Method |
| 3. | Determination Of Particle Size Distribution By Optical Microscopy |
| 4. | Estimation Of Optimum Concentration Of Various Glidants For The Flow Of Granules Using Angle Of Repose By Funnel Method |
| 5. | Effect Of Particle Size Reductions On Surface Area Of Powder |
| 6. | Evaluation Of Quality Control Parameters Of Tablets And Capsules |
| 7. | Study Of Extract Of Protein Binding |
PHARMACEUTICAL FORMULATIONS
| S.No. | CONTENT |
|---|---|
| 1. | Formulation And Evaluation Of Paraceutical Suspension |
| 2. | Formulation And Evaluation Of Multiple Emulsion |
| 3. | Formulation And Evaluation Of Neutralizing Capacity Of Antacid Gel |
| 4. | Formulation And Evaluation Of Cephalexin Dry Syrup |
| 5. | Preparation And In-Vitro Evaluation Of In –Situ Gels Of Ciprofloxacin For Ocular Delivery |
| 6. | Formulation And Evaluation Of Sustained Release Tablets –Matrix And Reservoir Type |
| 7. | Formulation And Evaluation Of Microscope |
© Designed & Hosted by YOGA'S IT Solutions.